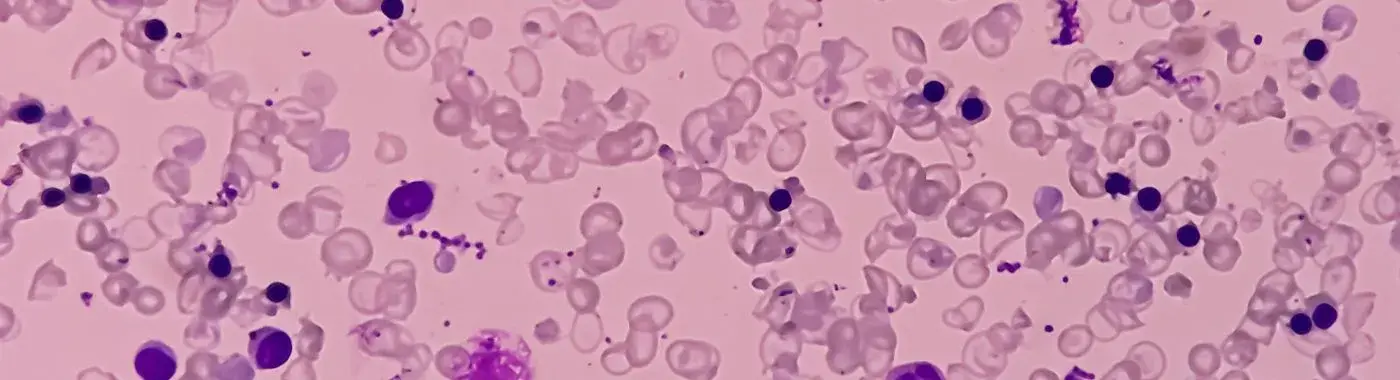
Hemolytic Anemia - Causes, Symptoms, Diagnosis, Treatment, and Prevention

- Diseases and Conditions
- Hemolytic Anemia - Causes, Symptoms, Diagnosis, Treatment, and Prevention
Hemolytic Anemia - Causes, Symptoms, Diagnosis, Treatment, and Prevention
Hemolytic Anemia: Understanding the Condition, Causes, Symptoms, and Treatment
Introduction
Hemolytic anemia is a condition characterized by the premature destruction of red blood cells, leading to a deficiency in the number of these vital cells in the bloodstream. This condition is significant because red blood cells are essential for transporting oxygen throughout the body. When their numbers dwindle, it can lead to a range of health issues, including fatigue, weakness, and more severe complications if left untreated. Understanding hemolytic anemia is crucial for early diagnosis and effective management, ensuring that individuals can maintain their health and quality of life.
Definition
What is Hemolytic Anemia?
Hemolytic anemia is a type of anemia that occurs when the body destroys red blood cells faster than it can produce them. This destruction can happen due to various factors, including autoimmune disorders, infections, genetic conditions, and exposure to certain drugs or toxins. The result is a reduced number of red blood cells, which can lead to symptoms of anemia, such as fatigue, pallor, and shortness of breath. Hemolytic anemia can be classified into two main categories: intrinsic (caused by defects within the red blood cells themselves) and extrinsic (caused by external factors affecting the red blood cells).
Causes and Risk Factors
Infectious/Environmental Causes
Certain infections can lead to hemolytic anemia. For example, infections caused by the bacteria Mycoplasma pneumoniae or the parasite Plasmodium (which causes malaria) can trigger the destruction of red blood cells. Environmental factors, such as exposure to certain chemicals or toxins, can also contribute to the development of hemolytic anemia.
Genetic/Autoimmune Causes
Genetic conditions, such as sickle cell disease and thalassemia, can lead to intrinsic hemolytic anemia. In these cases, the red blood cells are structurally abnormal, making them more susceptible to destruction. Autoimmune disorders, such as autoimmune hemolytic anemia (AIHA), occur when the immune system mistakenly attacks and destroys healthy red blood cells. This can be triggered by various factors, including infections, medications, or other underlying health conditions.
Lifestyle and Dietary Factors
While lifestyle and dietary factors are not direct causes of hemolytic anemia, they can influence overall health and the body’s ability to produce red blood cells. A diet lacking in essential nutrients, such as iron, vitamin B12, and folate, can contribute to anemia. Additionally, excessive alcohol consumption and certain lifestyle choices may exacerbate underlying conditions that lead to hemolytic anemia.
Key Risk Factors
Several risk factors can increase the likelihood of developing hemolytic anemia:
- Age: Certain types of hemolytic anemia are more common in specific age groups, such as infants or older adults.
- Gender: Some conditions, like autoimmune hemolytic anemia, may be more prevalent in women.
- Geographic Location: Certain genetic conditions, such as sickle cell disease, are more common in specific geographic regions.
- Underlying Conditions: Individuals with chronic diseases, such as lupus or HIV, may be at higher risk for developing hemolytic anemia.
Symptoms
Common Symptoms of Hemolytic Anemia
The symptoms of hemolytic anemia can vary depending on the severity of the condition and the underlying cause. Common symptoms include:
- Fatigue: A general feeling of tiredness or lack of energy.
- Pallor: Pale skin and mucous membranes due to reduced red blood cell count.
- Shortness of Breath: Difficulty breathing, especially during physical activity.
- Rapid Heartbeat: An increased heart rate as the body tries to compensate for low oxygen levels.
- Jaundice: Yellowing of the skin and eyes due to the buildup of bilirubin from the breakdown of red blood cells.
- Dark Urine: Urine may appear darker due to the presence of hemoglobin or bilirubin.
Warning Signs for Immediate Medical Attention
Certain symptoms may indicate a more severe form of hemolytic anemia or complications that require immediate medical attention. These include:
- Severe shortness of breath or chest pain.
- Sudden onset of jaundice.
- High fever or signs of infection.
- Severe abdominal or back pain.
- Confusion or altered mental status.
If you experience any of these symptoms, it is crucial to seek medical help promptly.
Diagnosis
Clinical Evaluation
The diagnosis of hemolytic anemia begins with a thorough clinical evaluation. This includes taking a detailed patient history to identify any potential risk factors, symptoms, and underlying conditions. A physical examination may reveal signs of anemia, such as pallor or jaundice.
Diagnostic Tests
Several diagnostic tests are used to confirm hemolytic anemia and determine its cause:
- Complete Blood Count (CBC): This test measures the number of red blood cells, hemoglobin levels, and other blood components.
- Reticulocyte Count: This test assesses the number of young red blood cells in the bloodstream, indicating the bone marrow's response to anemia.
- Peripheral Blood Smear: A sample of blood is examined under a microscope to look for abnormal red blood cell shapes or signs of destruction.
- Direct Coombs Test: This test helps determine if the immune system is attacking red blood cells.
- Bilirubin Levels: Elevated bilirubin levels can indicate increased breakdown of red blood cells.
- Haptoglobin Levels: Low levels of haptoglobin may suggest hemolysis.
Differential Diagnosis
When diagnosing hemolytic anemia, healthcare providers must consider other conditions that can cause similar symptoms, such as:
- Iron deficiency anemia
- Vitamin B12 deficiency anemia
- Aplastic anemia
- Thalassemia
A comprehensive evaluation helps ensure an accurate diagnosis and appropriate treatment plan.
Treatment Options
Medical Treatments
The treatment of hemolytic anemia depends on its underlying cause. Common medical treatments include:
- Corticosteroids: These medications can help reduce inflammation and suppress the immune system in cases of autoimmune hemolytic anemia.
- Immunosuppressants: In more severe cases, stronger immunosuppressive drugs may be necessary.
- Blood Transfusions: In cases of severe anemia, blood transfusions may be required to restore red blood cell levels.
- Splenectomy: Surgical removal of the spleen may be necessary in certain cases, especially if the spleen is involved in the destruction of red blood cells.
Non-Pharmacological Treatments
In addition to medical treatments, lifestyle modifications and dietary changes can support overall health and help manage hemolytic anemia:
- Dietary Changes: Consuming a balanced diet rich in iron, vitamin B12, and folate can help support red blood cell production. Foods such as leafy greens, lean meats, beans, and fortified cereals are beneficial.
- Hydration: Staying well-hydrated is essential for overall health and can help support blood volume.
- Avoiding Triggers: Identifying and avoiding any known triggers, such as certain medications or environmental factors, can help prevent exacerbations.
Special Considerations for Different Populations
- Pediatric Patients: Children with hemolytic anemia may require special considerations regarding growth and development. Close monitoring and tailored treatment plans are essential.
- Geriatric Patients: Older adults may have different underlying causes of hemolytic anemia and may require adjustments in treatment due to comorbidities and polypharmacy.
Complications
Potential Complications
If hemolytic anemia is left untreated or poorly managed, it can lead to several complications, including:
- Severe Anemia: This can result in significant fatigue, weakness, and decreased quality of life.
- Heart Problems: The heart may work harder to compensate for low oxygen levels, potentially leading to heart failure.
- Jaundice: Persistent jaundice can lead to complications such as gallstones due to increased bilirubin levels.
- Infections: Individuals with certain types of hemolytic anemia may be at increased risk for infections, especially if the spleen is removed.
Short-Term and Long-Term Complications
Short-term complications may include acute episodes of severe anemia, while long-term complications can involve chronic health issues related to ongoing hemolysis or the underlying cause of the anemia.
Prevention
Strategies for Prevention
While not all cases of hemolytic anemia can be prevented, certain strategies can help reduce the risk:
- Vaccinations: Staying up-to-date with vaccinations can help prevent infections that may trigger hemolytic anemia.
- Hygiene Practices: Good hygiene can reduce the risk of infections that may lead to hemolysis.
- Dietary Modifications: A balanced diet rich in essential nutrients can support overall health and red blood cell production.
- Lifestyle Changes: Avoiding excessive alcohol consumption and managing stress can contribute to better health outcomes.
Prognosis & Long-Term Outlook
Typical Course of the Disease
The prognosis for individuals with hemolytic anemia varies widely depending on the underlying cause, severity, and response to treatment. Some individuals may experience complete recovery, while others may require ongoing management.
Factors Influencing Prognosis
Several factors can influence the overall prognosis, including:
- Early Diagnosis: Prompt identification and treatment of hemolytic anemia can lead to better outcomes.
- Adherence to Treatment: Following the prescribed treatment plan and making necessary lifestyle changes can improve long-term health.
- Underlying Conditions: The presence of other health issues can complicate management and affect prognosis.
Frequently Asked Questions (FAQs)
- What are the main symptoms of hemolytic anemia? Common symptoms include fatigue, pallor, shortness of breath, rapid heartbeat, jaundice, and dark urine. If you experience severe symptoms, seek medical attention immediately.
- How is hemolytic anemia diagnosed? Diagnosis involves a clinical evaluation, blood tests (CBC, reticulocyte count, bilirubin levels), and possibly a peripheral blood smear or Coombs test to determine the cause.
- What are the treatment options for hemolytic anemia? Treatment options depend on the cause and may include corticosteroids, immunosuppressants, blood transfusions, or splenectomy. Lifestyle changes and dietary modifications can also help.
- Can hemolytic anemia be prevented? While not all cases can be prevented, strategies such as vaccinations, good hygiene, and a balanced diet can help reduce the risk.
- Is hemolytic anemia hereditary? Some forms of hemolytic anemia, such as sickle cell disease and thalassemia, are genetic. Others may be acquired due to autoimmune disorders or infections.
- How does hemolytic anemia affect daily life? Individuals with hemolytic anemia may experience fatigue and weakness, which can impact daily activities. Proper management can help improve quality of life.
- When should I see a doctor for hemolytic anemia? Seek medical attention if you experience severe fatigue, shortness of breath, jaundice, or any other concerning symptoms.
- What lifestyle changes can help manage hemolytic anemia? Eating a balanced diet rich in iron, vitamin B12, and folate, staying hydrated, and avoiding known triggers can help manage the condition.
- Are there any long-term complications of hemolytic anemia? Yes, potential complications include severe anemia, heart problems, jaundice, and increased risk of infections, especially if the spleen is removed.
- What is the long-term outlook for someone with hemolytic anemia? The prognosis varies based on the underlying cause and response to treatment. Early diagnosis and adherence to treatment can lead to better outcomes.
When to See a Doctor
It is essential to seek immediate medical attention if you experience any of the following serious symptoms:
- Severe shortness of breath or chest pain.
- Sudden onset of jaundice.
- High fever or signs of infection.
- Severe abdominal or back pain.
- Confusion or altered mental status.
Conclusion & Disclaimer
Hemolytic anemia is a complex condition that requires careful diagnosis and management. Understanding its causes, symptoms, and treatment options is crucial for individuals affected by this condition. Early intervention can lead to better health outcomes and improved quality of life. If you suspect you have hemolytic anemia or are experiencing related symptoms, consult a healthcare professional for personalized advice and treatment.
Disclaimer: This article is for informational purposes only and does not replace professional medical advice. Always consult a healthcare provider for medical concerns or questions regarding your health.


 Best Hospital Near me Chennai
Best Hospital Near me Chennai

